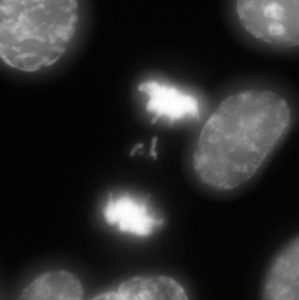

Genomic instability is a feature common in cancer that leads to aneuploidy and intra-tumor heterogeneity. Whole chromosome instability (CIN) results from underlying defects in mitotic chromosome segregation and leads to gains and losses of entire whole chromosomes. The ability of CIN cancer cells to ‘shuffle’ their genomic content can lead to gains of oncogenes, loss of tumor suppressors, and promotes tumor cell evolution. The resulting genomic heterogeneity between cells within a single tumor contributes to tumor cell evolution: promoting metastasis and as well as acquired drug resistance.
Genomic instability is a feature common in cancer that leads to aneuploidy and intra-tumor heterogeneity. Whole chromosome instability (CIN) results from underlying defects in mitotic chromosome segregation and leads to gains and losses of entire whole chromosomes. The ability of CIN cancer cells to ‘shuffle’ their genomic content can lead to gains of oncogenes, loss of tumor suppressors, and promotes tumor cell evolution. The resulting genomic heterogeneity between cells within a single tumor contributes to tumor cell evolution: promoting metastasis and as well as acquired drug resistance.
The existence of genomic instability represents a major difference between cancer cells and the normal cells from which they are derived. As such, manipulation of CIN may represent a point of weakness that can be exploited. Experimental evidence has suggested that both increasing and suppressing CIN may be therapeutically valuable, though the most appropriate mechanisms by which to alter CIN, as well as the cancer contexts where this would be most advantageous remain unclear. Using a combination of molecular and cell biological approaches, together with bioinformatics and imaging techniques, projects in the Manning lab aim to identify changes associated with genomic instability in cancer and exploit these changes to identify novel therapeutic targets and enhance cancer cell death.
Special thanks to the Richard and Susan Smith Family Foundation and In the Car studios for making this video possible!
Current projects in the Manning lab use a combination of molecular, genetic, and imaging approaches to:
- Identify and define cellular mechanisms that maintain chromatin structure and genome stability
- Understand how these pathways are corrupted in cancer cells
- Exploit defects in chromatin structure and mitotic progression as an intrinsic weakness in cancer cells

